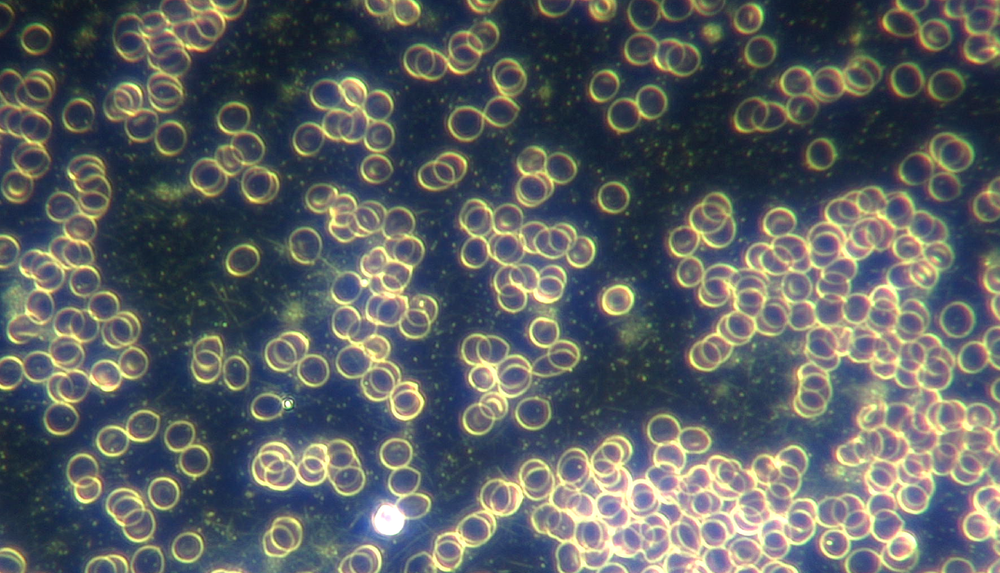

The Blood Never Lies
Ever wondered why you feel terrible but everything’s coming back “normal?” Viewing your blood cells under a microscope from a functional standpoint can give us a good reflection of your overall health. Changes in appearance can reveal patterns of inflammation, toxicity, and nutritional deficiencies that may be impacting your energy, mood, digestion, or immunity. Live Blood Analysis gives you a proactive, visual, and personalized understanding of your body, empowering you to make informed choices about nutrition, lifestyle, and supplementation.
How it works
By taking one single drop of blood from the client’s finger tip, and getting it onto a microscope slide and under the lens, we can magnify the image so powerfully that we see the red and white blood cells moving around and doing their business as if they were still inside the body. Cells obviously begin to die off over time, but within the first 45 minutes or so of the sample being under the microscope, the practitioner is able to give real-time feedback about the state of your blood - giving valuable recommendations based on visual observations of the state of your cells and the space between them.
Preventative medicine

Live Blood Analysis can help you stay one step ahead. Many imbalances and nutrient deficiencies begin long before they show up in standard lab tests or become diagnosable conditions. By observing your blood in real time, we can detect early signs of stress, inflammation, oxidative damage, or immune strain. This allows you to address these issues proactively with nutrition, lifestyle adjustments, and supplementation, helping prevent chronic conditions from developing down the road.
What can we see with Live Blood Analysis?

Nutrient Status & Deficiencies – Identify early signs of vitamin, mineral, and antioxidant deficiencies.Hydration Levels – Assess cellular hydration and overall fluid balance.Digestive & Gut Health Indicators – Observe signs of yeast overgrowth, bacterial imbalances, or digestive stress.Immune Function – Detect blood cell activity and signs of immune strain or imbalance.Inflammation & Oxidative Stress – Spot markers of inflammation and free radical damage.Toxicity Indicators – See evidence of heavy metals, environmental toxins, or metabolic waste.Blood Cell Shape & Vitality – Evaluate the health, activity, and life force of red and white blood cells.Circulation & Clotting Patterns – Observe how your blood flows and whether there are early signs of clotting issues.Early Functional Imbalances – Catch subtle issues before they become diagnosable disease.
Book an Appointment
Ready to see your blood? Appointments are available in Southern Alberta, Canada.
If you're interested but have questions, we’re happy to help!
